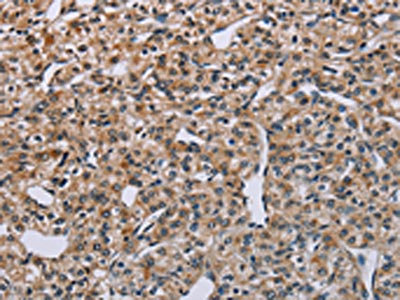

PNPT1 Antibody
-
中文名稱:PNPT1兔多克隆抗體
-
貨號:CSB-PA275832
-
規格:¥1100
-
圖片:
-
The image on the left is immunohistochemistry of paraffin-embedded Human prostate cancer tissue using CSB-PA275832(PNPT1 Antibody) at dilution 1/40, on the right is treated with synthetic peptide. (Original magnification: ×200)
-
The image on the left is immunohistochemistry of paraffin-embedded Human lung cancer tissue using CSB-PA275832(PNPT1 Antibody) at dilution 1/40, on the right is treated with synthetic peptide. (Original magnification: ×200)
-
-
其他:
產品詳情
-
Uniprot No.:
-
基因名:PNPT1
-
別名:PNPT1 antibody; PNPASE antibody; Polyribonucleotide nucleotidyltransferase 1 antibody; mitochondrial antibody; EC 2.7.7.8 antibody; 3'-5' RNA exonuclease OLD35 antibody; PNPase old-35 antibody; Polynucleotide phosphorylase 1 antibody; PNPase 1 antibody; Polynucleotide phosphorylase-like protein antibody
-
宿主:Rabbit
-
反應種屬:Human,Mouse
-
免疫原:Synthetic peptide of Human PNPT1
-
免疫原種屬:Homo sapiens (Human)
-
標記方式:Non-conjugated
-
抗體亞型:IgG
-
純化方式:Antigen affinity purification
-
濃度:It differs from different batches. Please contact us to confirm it.
-
保存緩沖液:-20°C, pH7.4 PBS, 0.05% NaN3, 40% Glycerol
-
產品提供形式:Liquid
-
應用范圍:ELISA,IHC
-
推薦稀釋比:
Application Recommended Dilution ELISA 1:2000-1:5000 IHC 1:50-1:200 -
Protocols:
-
儲存條件:Upon receipt, store at -20°C or -80°C. Avoid repeated freeze.
-
貨期:Basically, we can dispatch the products out in 1-3 working days after receiving your orders. Delivery time maybe differs from different purchasing way or location, please kindly consult your local distributors for specific delivery time.
-
用途:For Research Use Only. Not for use in diagnostic or therapeutic procedures.
相關產品
靶點詳情
-
功能:RNA-binding protein implicated in numerous RNA metabolic processes. Catalyzes the phosphorolysis of single-stranded polyribonucleotides processively in the 3'-to-5' direction. Mitochondrial intermembrane factor with RNA-processing exoribonulease activity. Component of the mitochondrial degradosome (mtEXO) complex, that degrades 3' overhang double-stranded RNA with a 3'-to-5' directionality in an ATP-dependent manner. Involved in the degradation of non-coding mitochondrial transcripts (MT-ncRNA) and tRNA-like molecules. Required for correct processing and polyadenylation of mitochondrial mRNAs. Plays a role as a cytoplasmic RNA import factor that mediates the translocation of small RNA components, like the 5S RNA, the RNA subunit of ribonuclease P and the mitochondrial RNA-processing (MRP) RNA, into the mitochondrial matrix. Plays a role in mitochondrial morphogenesis and respiration; regulates the expression of the electron transport chain (ETC) components at the mRNA and protein levels. In the cytoplasm, shows a 3'-to-5' exoribonuclease mediating mRNA degradation activity; degrades c-myc mRNA upon treatment with IFNB1/IFN-beta, resulting in a growth arrest in melanoma cells. Regulates the stability of specific mature miRNAs in melanoma cells; specifically and selectively degrades miR-221, preferentially. Plays also a role in RNA cell surveillance by cleaning up oxidized RNAs. Binds to the RNA subunit of ribonuclease P, MRP RNA and miR-221 microRNA.
-
基因功能參考文獻:
- The PNPT1 p.Arg136His and p.Pro140Leu variants in our subject showed 1) the mutated amino acids are highly conserved and our structural analysis supported them to be functionally deleterious; 2) The carrier frequencies of the variants are very low in populations (1:60.000), with no homozygous carriers found; 3) The RC complex amounts in the subject's myoblasts were functionally rescued by expression of wild-type PNPT1. PMID: 28645153
- Inhibition of homologous PNPase by citrate may represent an evolutionarily conserved communicative link between RNA degradation and central metabolism. PMID: 28334892
- In vitro rescue experiments, using exogenous expression of wild-type PNPT1 in patient fibroblasts, ameliorated the deficiencies in the OXPHOS complex protein expression, supporting the likely pathogenicity of these variants and the importance of Whole-exome sequencingin efficiently identifying rare genetic disease genes PMID: 27759031
- this study provides further evidence that hPNPase(old-35) is associated with global changes in cell cycle-associated genes and identifies potential gene targets for future investigation PMID: 24729470
- fresh insight into cellular pathways regulated by PNPT1 PMID: 24143183
- Interaction between PNPase and hSuv3 is essential for efficient mitochondrial RNA degradation. PMID: 23221631
- A mutation in PNPT1, encoding mitochondrial-RNA-import protein PNPase, causes hereditary hearing loss. PMID: 23084290
- Mutation in PNPT1, which encodes a polyribonucleotide nucleotidyltransferase, impairs RNA import into mitochondria and causes respiratory-chain deficiency. PMID: 23084291
- a novel role of nEGFR in radioresistance, and that is, upon ionizing radiation, nEGFR inactivates the ribonuclease activity of PNPase toward c-MYC mRNA through DNAPK-mediated Ser-776 phosphorylation PMID: 22815474
- The study provides structural and functional insights into hPNPase, which uses a KH pore to trap a long RNA 3' tail that is further delivered into an RNase PH channel for the degradation process. PMID: 22210891
- targeted overexpression of hPNPase(old-35) represents a novel strategy to selectively downregulate RNA expression and consequently intervene in a variety of pathophysiological conditions PMID: 21151174
- The data support an unanticipated role for PNPASE in mediating the translocation of RNAs into mitochondria. PMID: 20691904
- Inhibition of PNPase by shRNA or stable overexpression of miR-221 protected melanoma cells from IFN-beta-mediated growth inhibition, accentuating the importance of PNPase induction and miR-221 down-regulation in mediating IFN-beta action. PMID: 20547861
- Protein-protein interactions between human exosome components support the assembly of RNase PH-type subunits into a six-membered PNPase-like ring PMID: 12419256
- an important role for hPNPase(old-35)in growth control associated with terminal differentiation and cellular senescence. PMID: 12473748
- the molecular mechanism of the growth-arresting property of hPNPaseold-35 PMID: 12721301
- demonstrate that the hPNPase is localized in mitochondria; finding suggests the involvement of mitochondrial RNA metabolism in cellular senescence PMID: 12798676
- analysis of domains of human polynucleotide phosphorylase (hPNPaseOLD-35) mediating cellular senescence PMID: 16055741
- Targeted overexpression of hPNPase(old-35) might be a novel therapeutic strategy for c-myc-overexpressing and IFN-resistant tumors, such as melanomas. PMID: 16410805
- human PNPase mRNA upregulation by beta-interferon has no effect on protein level in melanoma cell lines PMID: 16505900
- PNPase localization to the mitochondrial intermembrane space suggests a unique role distinct from its highly conserved function in RNA processing in chloroplasts and bacteria. PMID: 16966379
- Combined, the data demonstrate an unexpected IMS localization and a key role for PNPase in maintaining mitochondrial homeostasis. PMID: 16966381
- A novel pathway by which an evolutionary conserved RNA-metabolizing enzyme, hPNPase(old-35), regulates cell growth and viability. PMID: 17804700
- recent advances in understanding the various roles of hPNPase both within and potentially outside of the mitochondria [review] PMID: 17983748
- In this work, the degradation, polymerization, and RNA-binding properties of the human PNPase were analyzed and compared to its bacterial and organellar counterparts. PMID: 18083836
- Involvement of human polynucleotide phosphorylase in mtRNA degradation was studied. PMID: 18083837
- The complex of hSUV3-hPNPase is an integral entity for efficient degradation of structured RNA and may be the long sought RNA-degrading complex in the mammalian mitochondria. PMID: 19509288
- maintained expression and even up-regulation of some (PNPT1, PMPCB, HMMR/RHAMM, BSG and ERCC1) tumor associated antigens in CD40-activated leukemic cells. PMID: 19580345
顯示更多
收起更多
-
相關疾病:Combined oxidative phosphorylation deficiency 13 (COXPD13); Deafness, autosomal recessive, 70 (DFNB70)
-
亞細胞定位:Cytoplasm. Mitochondrion matrix. Mitochondrion intermembrane space; Peripheral membrane protein.
-
蛋白家族:Polyribonucleotide nucleotidyltransferase family
-
數據庫鏈接:
Most popular with customers
-
-
YWHAB Recombinant Monoclonal Antibody
Applications: ELISA, WB, IHC, IF, FC
Species Reactivity: Human, Mouse, Rat
-
-
-
-
-
-